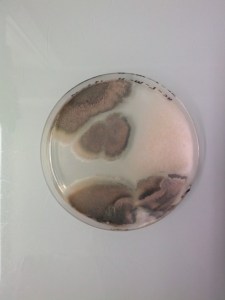
arts
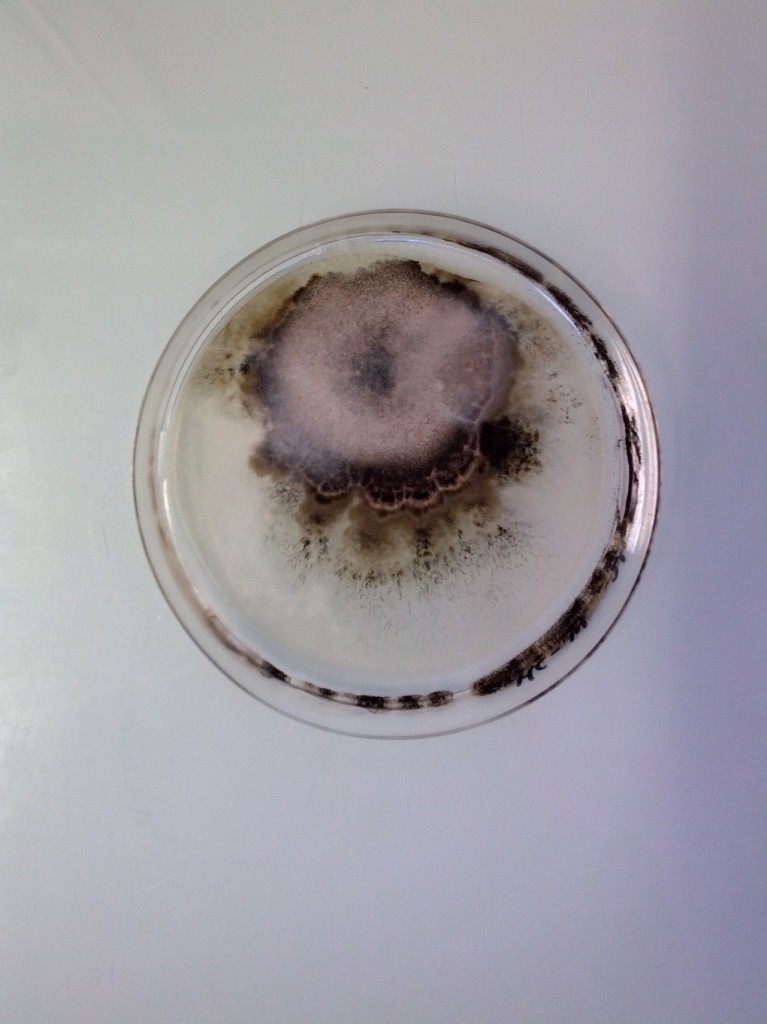
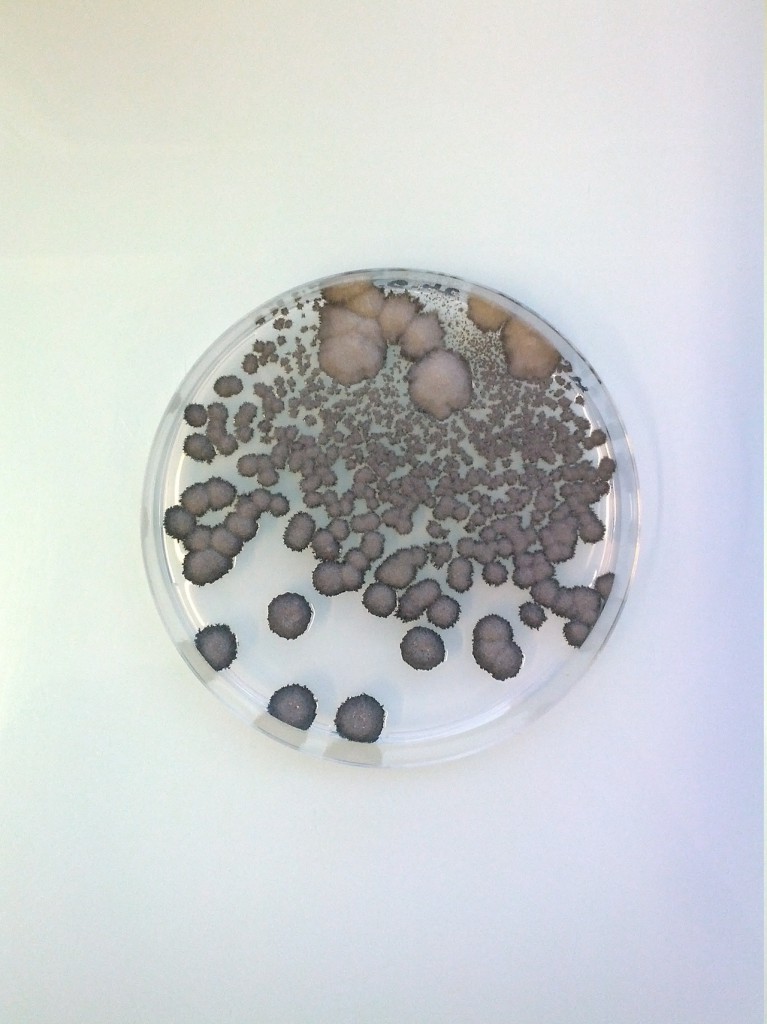

Partager :
- Partager sur X(ouvre dans une nouvelle fenêtre) X
- Partager sur Tumblr(ouvre dans une nouvelle fenêtre) Tumblr
- Plus
- Partager sur Facebook(ouvre dans une nouvelle fenêtre) Facebook
- Imprimer(ouvre dans une nouvelle fenêtre) Imprimer
- Envoyer un lien par e-mail à un ami(ouvre dans une nouvelle fenêtre) E-mail
- Partager sur WhatsApp(ouvre dans une nouvelle fenêtre) WhatsApp
- Partager sur Mastodon(ouvre dans une nouvelle fenêtre) Mastodon